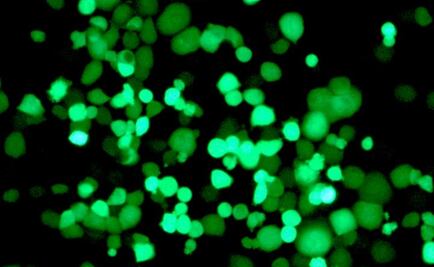
Crean virus que atacan de forma selectiva a las células tumorales

Las variantes genéticas que afectan el funcionamiento de nuestro cerebro pueden ser la razón

Las variantes genéticas que afectan el funcionamiento de nuestro cerebro pueden ser la razón

Descubre por qué sólo de ver comida puede hacer que se te haga la boca agua

Descubre por qué sólo de ver comida puede hacer que se te haga la boca agua

La información fue publicada en un estudio de una universidad sueca
El tratamiento convencional del cáncer puede provocar efectos secundarios no deseados como consecuencia de una poca selectividad

Es la primera vez que se otorga tal autorización a fin de impedir que las mujeres transmitan enfermedades genéticas

Una nueva forma de dopaje en atletas podría ser encubierto gracias a los avances en terapia génica

Los mismos genes que son beneficiosos en la infancia son perjudiciales en la vejez

La mayoría de los rasgos están genéticamente controlados hasta cierto punto

El procedimiento realizado en México para lograr la concepción de un bebé con material genético de tres personas abre un debate bioético